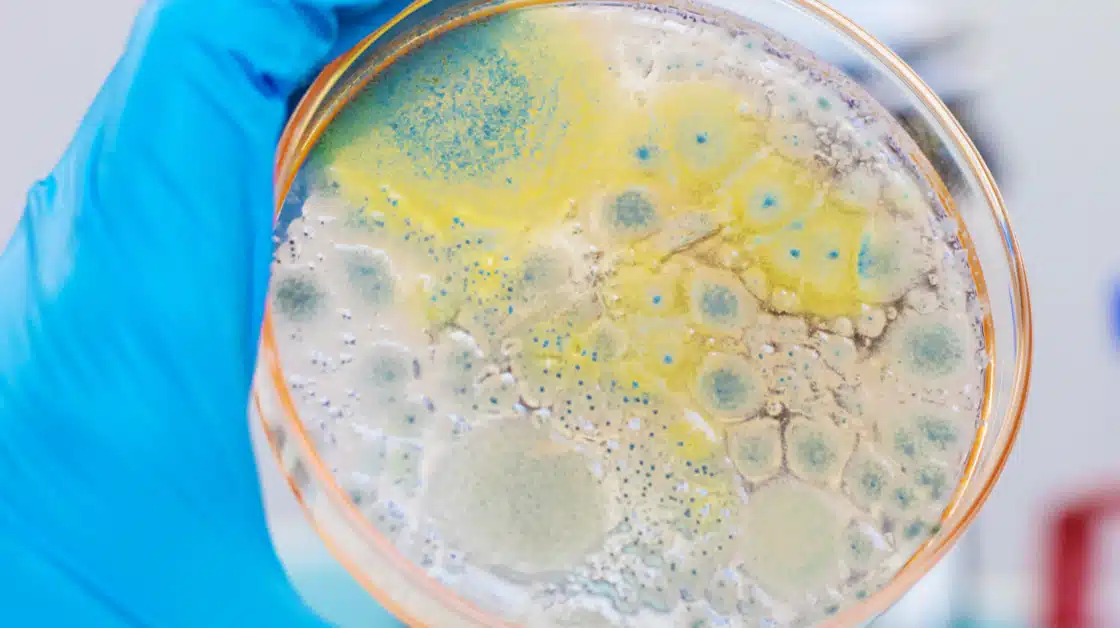

Facility Qualification (EMPQ & EM)
Get Your Cleanroom Qualified — Faster, Smarter, and Audit-Ready
Launching or expanding a controlled environment requires careful planning, technical expertise, and the ability to execute quickly without compromising compliance. Gillson Sciences provides comprehensive Environmental Monitoring Performance Qualification (EMPQ) support designed to reduce risk, save time, and help your facility move toward full operation with confidence.

Microbiological Cleaning Validation
USP <1072> Disinfectant Effectiveness:
Regulators expect documented proof that your disinfectants and sanitization program actually control microbial contamination within your facility. We help you demonstrate:
- Disinfectant efficacy against relevant organisms
- Surface challenge studies
- Contact time verification
- Disinfectant rotation justification
- Environmental isolate testing
- Alignment with Contamination Control Strategy (CCS)
Outcome: A defensible microbial cleaning program backed by real data — not assumptions.

Chemical Residue Cleaning Validation
Cleaning Agent & API Residue Testing:
The FDA requires evidence that cleaning procedures remove residual chemicals and active ingredients to safe, justified limits.
Gillson supports:
- Residual cleaning agent analysis
- API carryover testing
- Swab and rinse sample analysis
- Recovery studies and method suitability
- Limit calculations and validation support
- Cross-contamination risk mitigation
Outcome: Data that proves your cleaning process works — every time.

Why Both Are Required for Compliance
Cleaning validation is not complete unless you address: Microbial risk — controlled through USP <1072> validation, Chemical risk — controlled through residue testing. Facilities that overlook one side create inspection exposure, delayed approvals, and unnecessary remediation costs.
We help you close both gaps at once.
Why Pharma Teams Choose Gillson Sciences

Faster Turnaround. Real Partnership.
- Direct access to experienced scientists
- Responsive communication — not ticket systems
- Flexible scheduling aligned with your timeline

GMP Expertise That Prevents Delays
- FDA-registered, GMP-compliant laboratory
- Experience across multiple facility types and processes
- Guidance that helps avoid common validation pitfalls

One Partner Instead of Multiple Vendors
- Microbial and chemical testing under one program
- Streamlined documentation
- Consistent data package for audits and submissions

